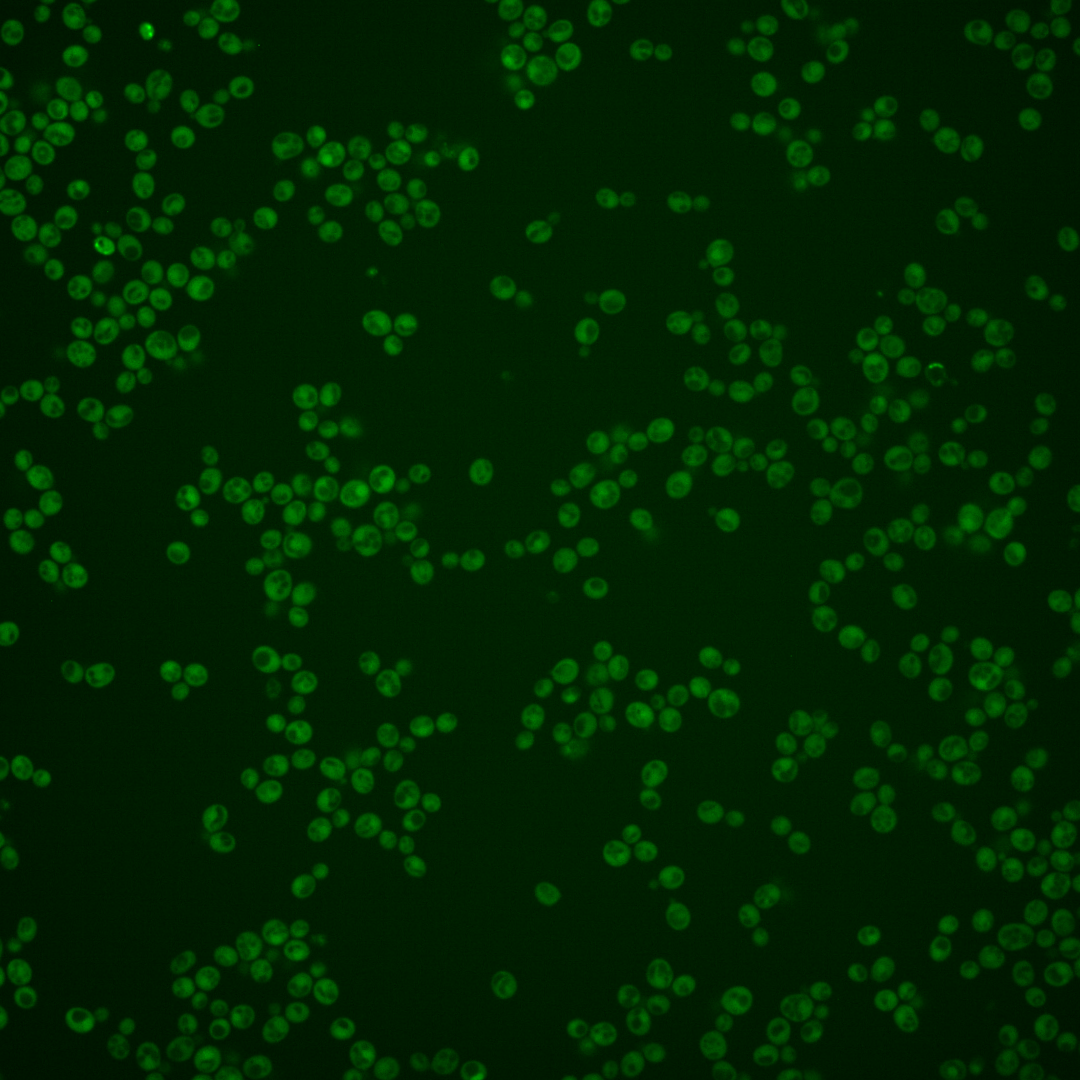
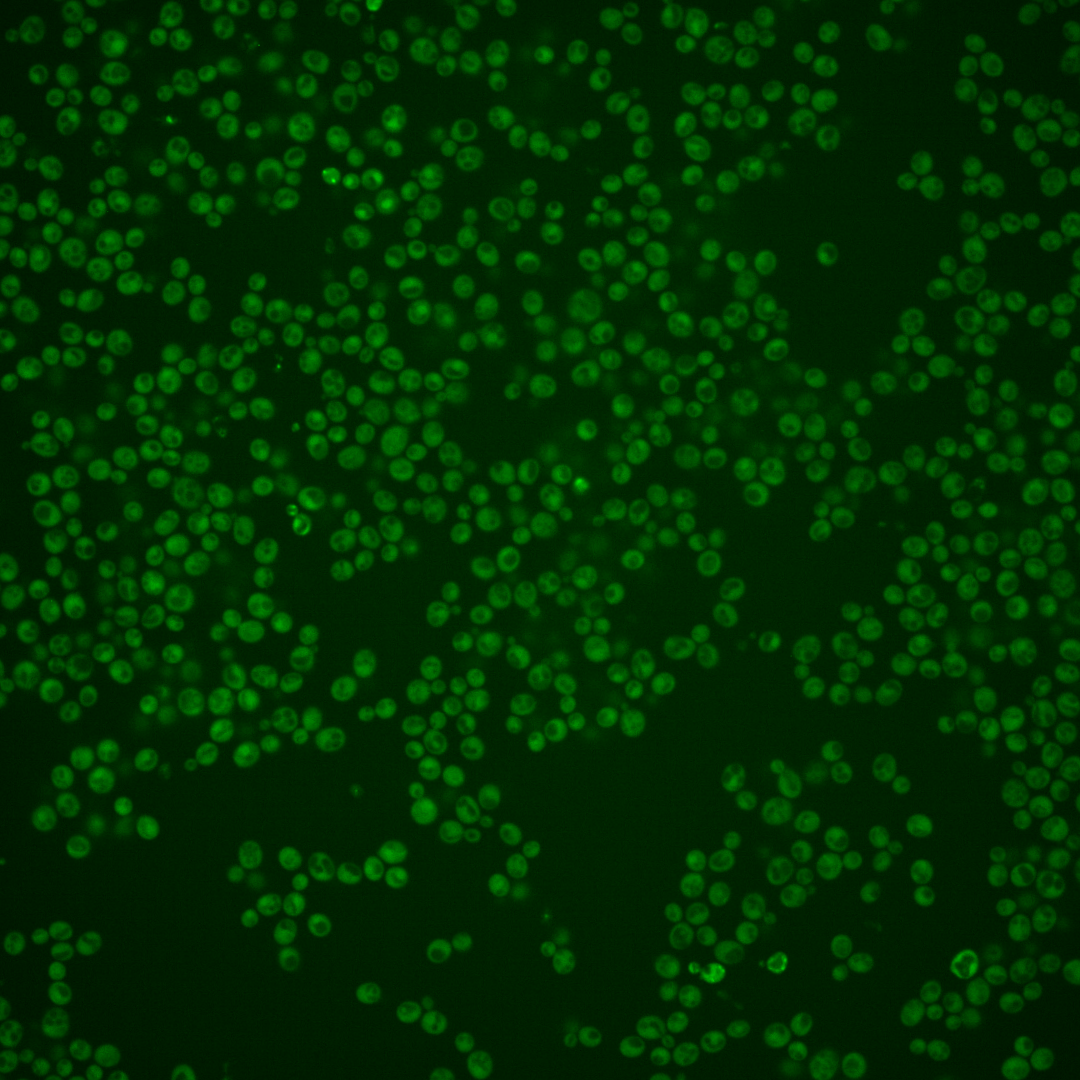
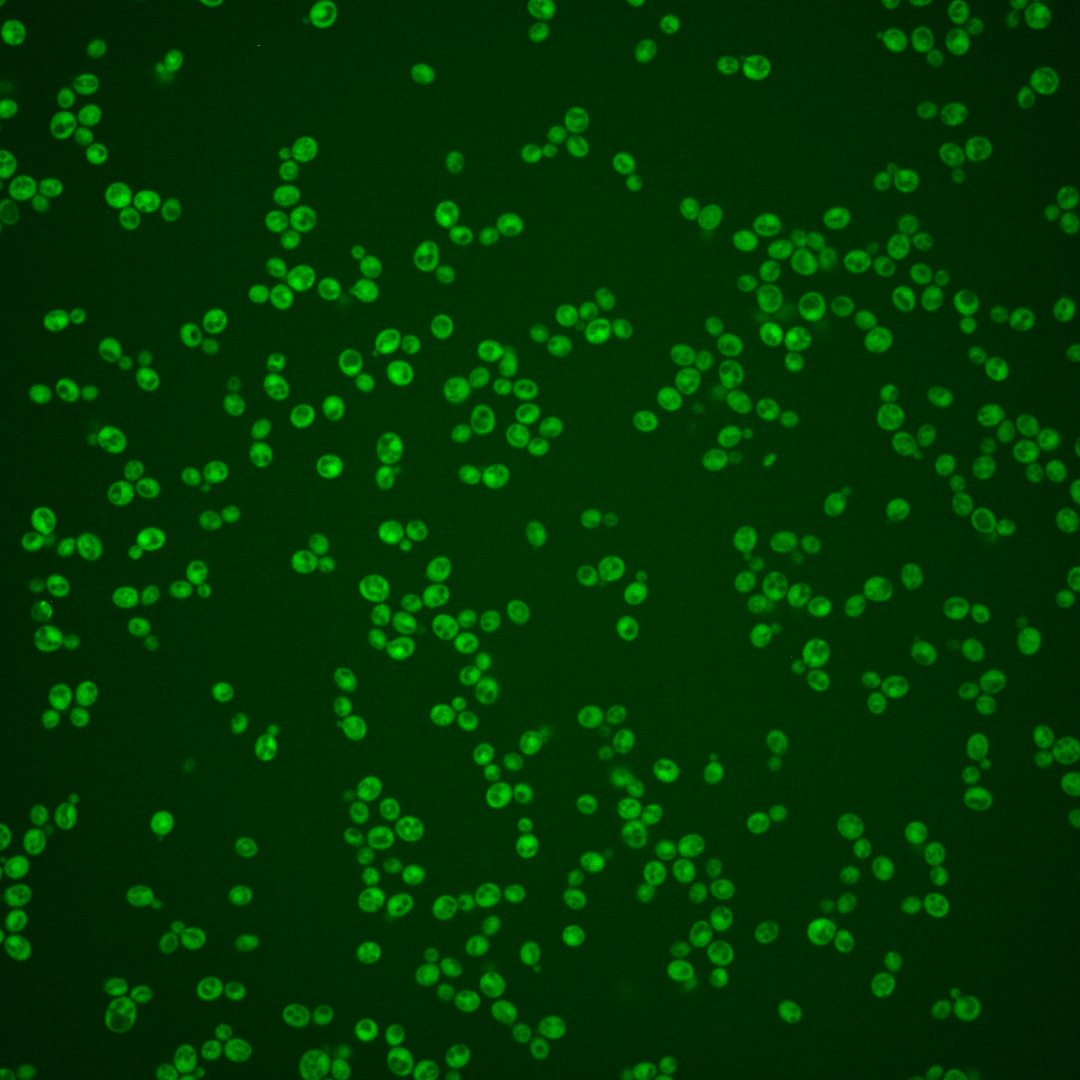
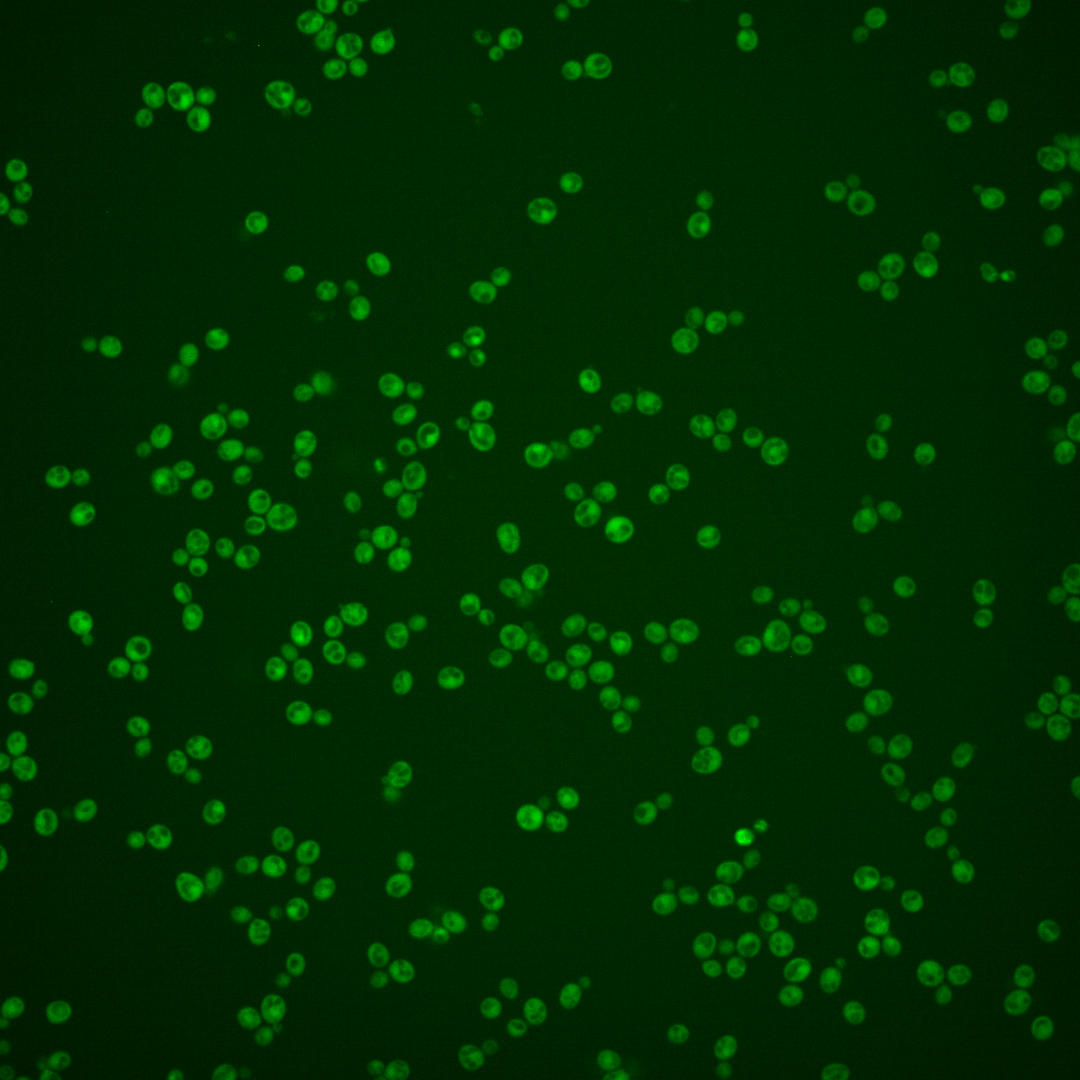
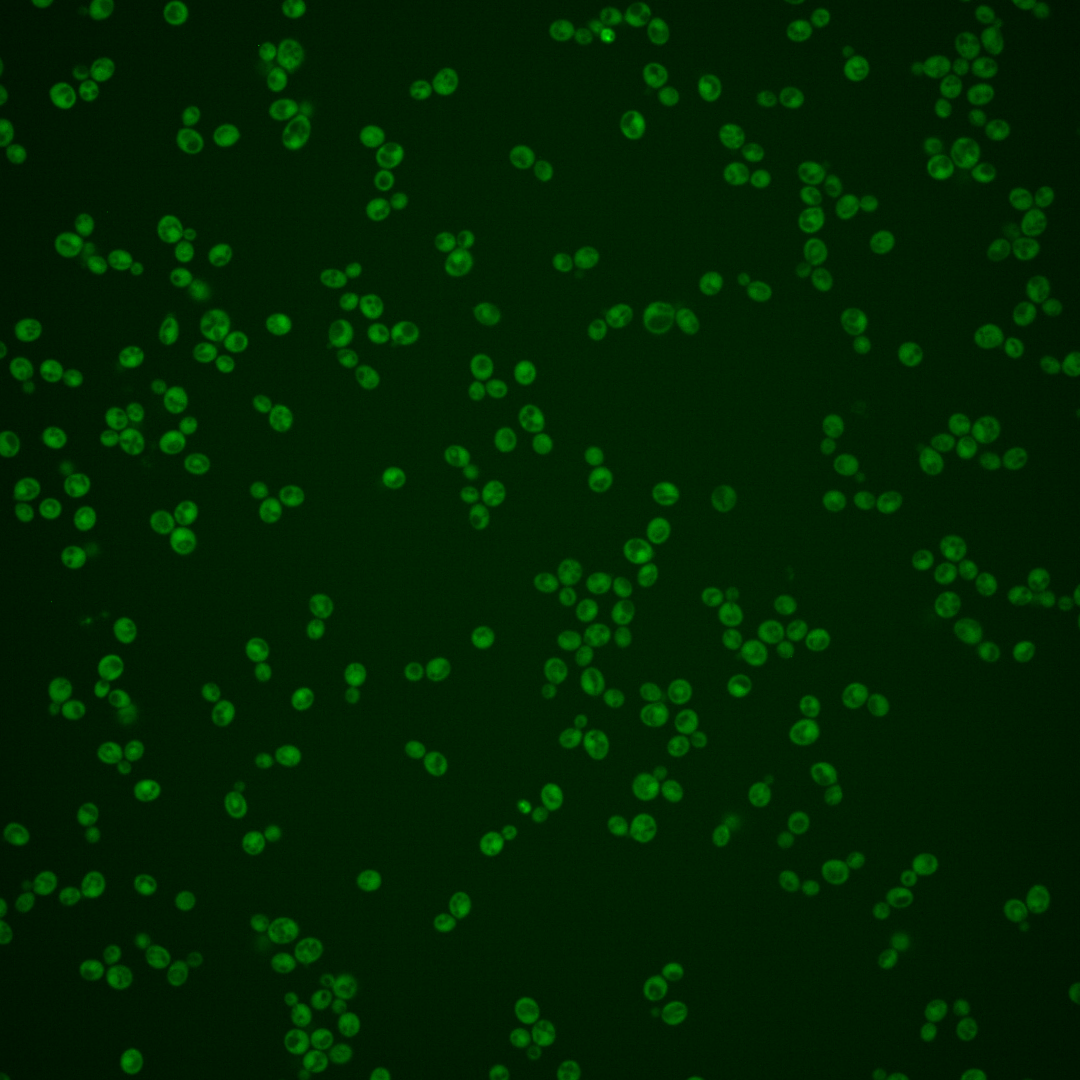
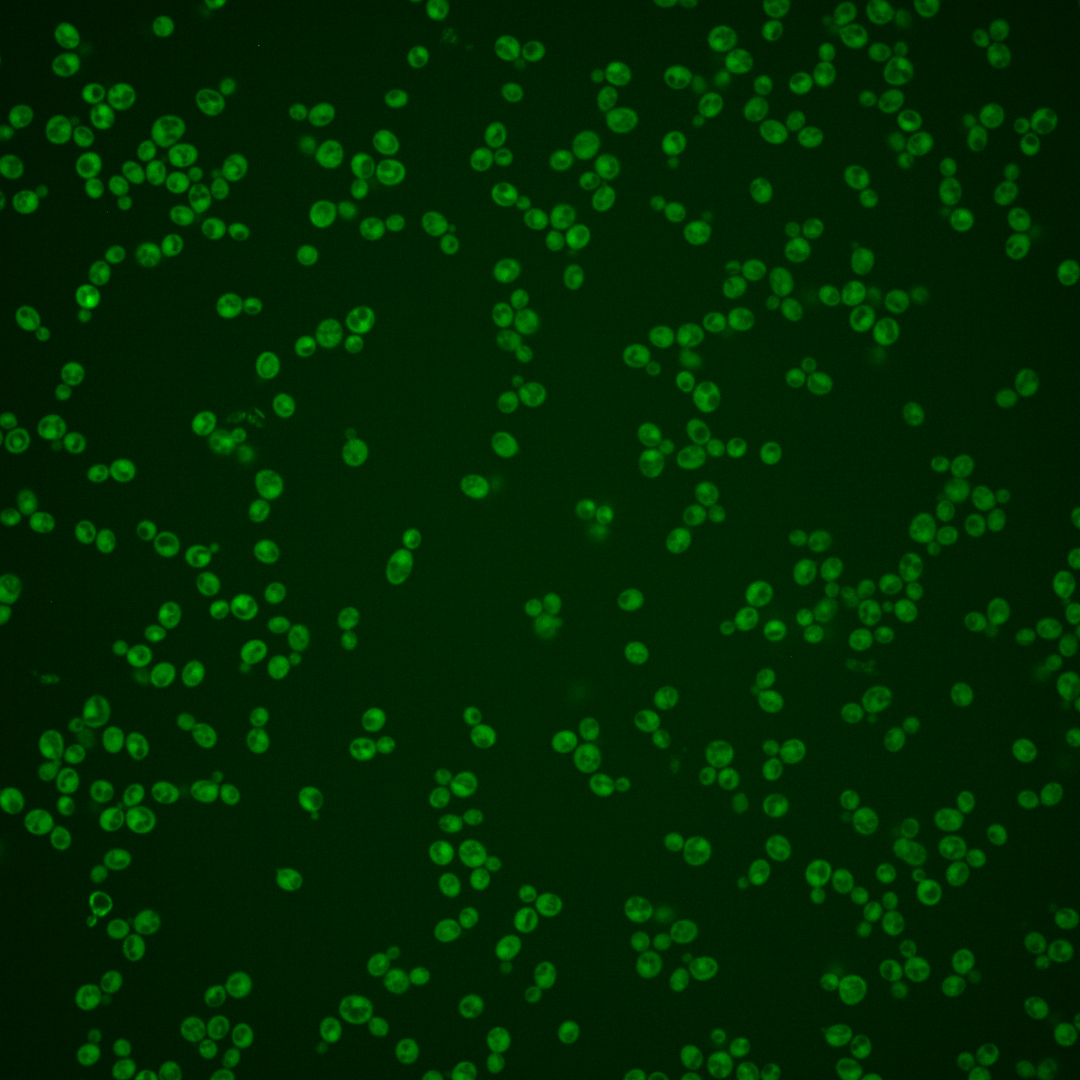

| Standard name | |
|---|---|
| Human Ortholog | |
| Description | Protein involved in 5.8S rRNA processing; Ccr4p-like RNase required for correct 3'-end formation of 5.8S rRNA at site E; similar to Ngl1p; NGL2 has a paralog, NGL3, that arose from the whole genome duplication |
Micrographs




















































































Sub-cellular Localization
Yeast GFP Assignment
Protein Abundance
Localization Change
External localization resources
| ensLOC | DeepLoc | |||||||||||||||||||||||
|---|---|---|---|---|---|---|---|---|---|---|---|---|---|---|---|---|---|---|---|---|---|---|---|---|
| Localization | WT1 | WT2 | WT3 | RAP60 | RAP140 | RAP220 | RAP300 | RAP380 | RAP460 | RAP540 | RAP620 | RAP700 | HU80 | HU120 | HU160 | rpd3Δ_1 | rpd3Δ_2 | rpd3Δ_3 | WT1 | WT2 | WT3 | AF100 | AF140 | AF180 |
| Cortical Patches | 0 | 0 | 0 | 0 | 0 | 0 | 0 | 0 | 0 | 0 | 0 | 0 | 0 | 0 | 0 | 0 | 1 | 0 | 0 | 0 | 0 | 1 | 1 | 4 |
| Bud | 1 | 2 | 5 | 0 | 4 | 1 | 2 | 3 | 1 | 4 | 0 | 5 | 1 | 1 | 1 | 1 | 0 | 0 | 0 | 0 | 0 | 0 | 3 | 6 |
| Bud Neck | 0 | 0 | 1 | 0 | 0 | 0 | 0 | 0 | 0 | 0 | 0 | 0 | 0 | 0 | 0 | 0 | 0 | 0 | 0 | 0 | 0 | 0 | 0 | 0 |
| Bud Site | 0 | 0 | 0 | 0 | 0 | 0 | 0 | 1 | 1 | 0 | 1 | 0 | 0 | 0 | 0 | 0 | 0 | 0 | – | – | – | – | – | – |
| Cell Periphery | 2 | 3 | 0 | 0 | 0 | 3 | 1 | 1 | 0 | 0 | 1 | 1 | 1 | 5 | 3 | 8 | 11 | 7 | 0 | 0 | 0 | 0 | 0 | 1 |
| Cytoplasm | 224 | 237 | 113 | 41 | 126 | 149 | 123 | 187 | 80 | 86 | 92 | 109 | 472 | 510 | 515 | 558 | 570 | 494 | 223 | 230 | 111 | 227 | 272 | 305 |
| Endoplasmic Reticulum | 1 | 1 | 0 | 0 | 1 | 2 | 1 | 0 | 0 | 0 | 0 | 0 | 1 | 2 | 1 | 27 | 22 | 22 | 1 | 0 | 0 | 2 | 1 | 6 |
| Endosome | 1 | 0 | 0 | 0 | 0 | 0 | 0 | 0 | 0 | 0 | 0 | 0 | 0 | 1 | 0 | 2 | 4 | 7 | 3 | 0 | 0 | 2 | 6 | 5 |
| Golgi | 1 | 1 | 0 | 0 | 0 | 0 | 0 | 0 | 0 | 0 | 0 | 0 | 0 | 2 | 0 | 0 | 2 | 1 | 2 | 1 | 0 | 0 | 1 | 0 |
| Mitochondria | 11 | 0 | 9 | 4 | 14 | 51 | 77 | 87 | 55 | 71 | 119 | 81 | 0 | 2 | 1 | 5 | 6 | 3 | 1 | 3 | 2 | 2 | 6 | 9 |
| Nucleus | 0 | 0 | 0 | 0 | 0 | 1 | 1 | 1 | 1 | 0 | 4 | 1 | 0 | 1 | 2 | 3 | 5 | 3 | 0 | 1 | 0 | 0 | 0 | 0 |
| Nuclear Periphery | 2 | 1 | 0 | 0 | 0 | 0 | 0 | 1 | 0 | 2 | 0 | 1 | 0 | 0 | 0 | 0 | 0 | 0 | 1 | 0 | 0 | 1 | 0 | 0 |
| Nucleolus | 0 | 0 | 0 | 0 | 0 | 0 | 1 | 0 | 1 | 0 | 0 | 0 | 0 | 0 | 0 | 0 | 0 | 0 | 0 | 0 | 0 | 0 | 0 | 0 |
| Peroxisomes | 0 | 0 | 0 | 0 | 0 | 0 | 0 | 0 | 0 | 0 | 0 | 0 | 0 | 0 | 0 | 0 | 0 | 0 | 0 | 0 | 0 | 0 | 0 | 0 |
| SpindlePole | 0 | 0 | 1 | 0 | 0 | 0 | 0 | 0 | 0 | 1 | 0 | 2 | 0 | 0 | 0 | 2 | 1 | 0 | 1 | 0 | 0 | 0 | 6 | 7 |
| Vac/Vac Membrane | 0 | 0 | 0 | 0 | 0 | 0 | 1 | 0 | 0 | 0 | 2 | 1 | 1 | 0 | 1 | 10 | 22 | 9 | 7 | 1 | 0 | 3 | 6 | 11 |
| Unique Cell Count | 233 | 240 | 119 | 41 | 134 | 168 | 160 | 227 | 109 | 126 | 165 | 156 | 473 | 516 | 520 | 569 | 593 | 512 | 245 | 243 | 118 | 245 | 312 | 365 |
| Labelled Cell Count | 243 | 245 | 129 | 45 | 145 | 207 | 207 | 281 | 139 | 164 | 219 | 201 | 476 | 524 | 524 | 616 | 644 | 546 | 245 | 243 | 118 | 245 | 312 | 365 |
Yeast GFP Assignment
Protein Abundance
| Screen | WT1 | WT2 | WT3 | RAP60 | RAP140 | RAP220 | RAP300 | RAP380 | RAP460 | RAP540 | RAP620 | RAP700 | HU80 | HU120 | HU160 | rpd3Δ_1 | rpd3Δ_2 | rpd3Δ_3 | AF100 | AF140 | AF180 |
|---|---|---|---|---|---|---|---|---|---|---|---|---|---|---|---|---|---|---|---|---|---|
| Mean Cell GFP Intensity (1e-4) | 5.0 | 6.1 | 4.6 | 4.3 | 4.2 | 3.6 | 3.0 | 3.4 | 3.4 | 3.5 | 3.1 | 3.2 | 6.1 | 5.8 | 5.8 | 5.8 | 7.0 | 6.4 | 5.0 | 4.8 | 5.6 |
| Std Deviation (1e-4) | 0.7 | 0.7 | 0.8 | 0.6 | 1.3 | 0.8 | 0.7 | 1.0 | 0.8 | 1.8 | 0.9 | 1.3 | 0.9 | 1.1 | 1.2 | 1.2 | 1.4 | 1.1 | 0.9 | 1.0 | 1.3 |
| Intensity Change (Log2) | – | – | – | -0.1 | -0.14 | -0.38 | -0.65 | -0.45 | -0.46 | -0.42 | -0.57 | -0.55 | 0.39 | 0.33 | 0.31 | 0.31 | 0.58 | 0.47 | 0.1 | 0.05 | 0.27 |
Localization Change
| Localization | RAP60 | RAP140 | RAP220 | RAP300 | RAP380 | RAP460 | RAP540 | RAP620 | RAP700 | HU80 | HU120 | HU160 | rpd3Δ_1 | rpd3Δ_2 | rpd3Δ_3 |
|---|---|---|---|---|---|---|---|---|---|---|---|---|---|---|---|
| Cortical Patches | 0 | 0 | 0 | 0 | 0 | 0 | 0 | 0 | 0 | 0 | 0 | 0 | 0 | 0 | 0 |
| Bud | 0 | 0 | 0 | 0 | 0 | 0 | 0 | 0 | 0 | 0 | 0 | 0 | 0 | 0 | 0 |
| Bud Neck | 0 | 0 | 0 | 0 | 0 | 0 | 0 | 0 | 0 | 0 | 0 | 0 | 0 | 0 | 0 |
| Bud Site | 0 | 0 | 0 | 0 | 0 | 0 | 0 | 0 | 0 | 0 | 0 | 0 | 0 | 0 | 0 |
| Cell Periphery | 0 | 0 | 0 | 0 | 0 | 0 | 0 | 0 | 0 | 0 | 0 | 0 | 0 | 0 | 0 |
| Cytoplasm | 1.5 | -0.3 | -1.9 | -4.1 | -3.3 | -4.5 | -5.3 | -7.3 | -5.2 | 4.4 | 2.8 | 3.1 | 2.0 | 0.6 | 0.8 |
| Endoplasmic Reticulum | 0 | 0 | 0 | 0 | 0 | 0 | 0 | 0 | 0 | 0 | 0 | 0 | 0 | 0 | 0 |
| Endosome | 0 | 0 | 0 | 0 | 0 | 0 | 0 | 0 | 0 | 0 | 0 | 0 | 0 | 0 | 0 |
| Golgi | 0 | 0 | 0 | 0 | 0 | 0 | 0 | 0 | 0 | 0 | 0 | 0 | 0 | 0 | 0 |
| Mitochondria | 0 | 0 | 0 | 0 | 0 | 0 | 0 | 0 | 0 | 0 | 0 | 0 | 0 | 0 | 0 |
| Nucleus | 0 | 0 | 0 | 0 | 0 | 0 | 0 | 0 | 0 | 0 | 0 | 0 | 0 | 0 | 0 |
| Nuclear Periphery | 0 | 0 | 0 | 0 | 0 | 0 | 0 | 0 | 0 | 0 | 0 | 0 | 0 | 0 | 0 |
| Nucleolus | 0 | 0 | 0 | 0 | 0 | 0 | 0 | 0 | 0 | 0 | 0 | 0 | 0 | 0 | 0 |
| Peroxisomes | 0 | 0 | 0 | 0 | 0 | 0 | 0 | 0 | 0 | 0 | 0 | 0 | 0 | 0 | 0 |
| SpindlePole | 0 | 0 | 0 | 0 | 0 | 0 | 0 | 0 | 0 | 0 | 0 | 0 | 0 | 0 | 0 |
| Vacuole | 0 | 0 | 0 | 0 | 0 | 0 | 0 | 0 | 0 | 0 | 0 | 0 | 0 | 0 | 0 |
External localization resources
Images






























Protein Concentration and Protein Localization Data
| R1 | R2 | R3 | ||||||||||||||||
|---|---|---|---|---|---|---|---|---|---|---|---|---|---|---|---|---|---|---|
| G1 Pre-START | G1 Post-START | S/G2 | Metaphase | Anaphase | Telophase | G1 Pre-START | G1 Post-START | S/G2 | Metaphase | Anaphase | Telophase | G1 Pre-START | G1 Post-START | S/G2 | Metaphase | Anaphase | Telophase | |
| Concentration | – | – | – | – | – | – | – | – | – | – | – | – | – | – | – | – | – | – |
| Actin | – | – | – | – | – | – | 0.055 | 0.014 | 0.0432 | 0.0083 | 0.0137 | 0.0116 | – | – | – | – | – | – |
| Bud | – | – | – | – | – | – | 0.002 | 0.0008 | 0.0009 | 0.0003 | 0.0012 | 0.0068 | – | – | – | – | – | – |
| Bud Neck | – | – | – | – | – | – | 0.0116 | 0.0003 | 0.0005 | 0.0005 | 0.0008 | 0.0003 | – | – | – | – | – | – |
| Bud Periphery | – | – | – | – | – | – | 0.0021 | 0.0005 | 0.0013 | 0.0002 | 0.0019 | 0.0061 | – | – | – | – | – | – |
| Bud Site | – | – | – | – | – | – | 0.0057 | 0.0087 | 0.0082 | 0.0009 | 0.0038 | 0.0002 | – | – | – | – | – | – |
| Cell Periphery | – | – | – | – | – | – | 0.0005 | 0.0003 | 0.001 | 0.0001 | 0.0004 | 0 | – | – | – | – | – | – |
| Cytoplasm | – | – | – | – | – | – | 0.3779 | 0.6194 | 0.567 | 0.5929 | 0.4579 | 0.68 | – | – | – | – | – | – |
| Cytoplasmic Foci | – | – | – | – | – | – | 0.0422 | 0.018 | 0.0173 | 0.0419 | 0.0435 | 0.0093 | – | – | – | – | – | – |
| Eisosomes | – | – | – | – | – | – | 0.0003 | 0.0001 | 0.0003 | 0 | 0.0001 | 0 | – | – | – | – | – | – |
| Endoplasmic Reticulum | – | – | – | – | – | – | 0.007 | 0.0035 | 0.0035 | 0.0025 | 0.0024 | 0.0013 | – | – | – | – | – | – |
| Endosome | – | – | – | – | – | – | 0.0265 | 0.006 | 0.0219 | 0.0283 | 0.0361 | 0.0054 | – | – | – | – | – | – |
| Golgi | – | – | – | – | – | – | 0.008 | 0.0055 | 0.0145 | 0.0131 | 0.023 | 0.0044 | – | – | – | – | – | – |
| Lipid Particles | – | – | – | – | – | – | 0.0312 | 0.0006 | 0.0012 | 0.0066 | 0.0566 | 0.0026 | – | – | – | – | – | – |
| Mitochondria | – | – | – | – | – | – | 0.0072 | 0.0007 | 0.0067 | 0.0012 | 0.0124 | 0.0024 | – | – | – | – | – | – |
| None | – | – | – | – | – | – | 0.3736 | 0.3108 | 0.3012 | 0.2861 | 0.3289 | 0.2616 | – | – | – | – | – | – |
| Nuclear Periphery | – | – | – | – | – | – | 0.0155 | 0.0009 | 0.0006 | 0.0017 | 0.001 | 0.0004 | – | – | – | – | – | – |
| Nucleolus | – | – | – | – | – | – | 0.0009 | 0.0001 | 0.0001 | 0.0001 | 0.0002 | 0 | – | – | – | – | – | – |
| Nucleus | – | – | – | – | – | – | 0.0079 | 0.001 | 0.0007 | 0.0015 | 0.0006 | 0.0009 | – | – | – | – | – | – |
| Peroxisomes | – | – | – | – | – | – | 0.0091 | 0.0062 | 0.0062 | 0.0085 | 0.012 | 0.0055 | – | – | – | – | – | – |
| Punctate Nuclear | – | – | – | – | – | – | 0.0084 | 0.0009 | 0.0004 | 0.0013 | 0.0013 | 0.0004 | – | – | – | – | – | – |
| Vacuole | – | – | – | – | – | – | 0.0039 | 0.0014 | 0.0031 | 0.0034 | 0.0015 | 0.0006 | – | – | – | – | – | – |
| Vacuole Periphery | – | – | – | – | – | – | 0.0034 | 0.0002 | 0.0003 | 0.0006 | 0.0007 | 0.0001 | – | – | – | – | – | – |
Sequencing Data
| R1 | R2 | |||||||||
|---|---|---|---|---|---|---|---|---|---|---|
| G1 Post-START | S/G2 | Metaphase | Anaphase | Telophase | G1 Post-START | S/G2 | Metaphase | Anaphase | Telophase | |
| Gene Expression | 18.889 | 18.4786 | 13.7119 | 16.0096 | 15.2488 | 18.5224 | 20.9386 | 18.698 | 20.2013 | 16.7878 |
| Translational Efficiency | 1.4065 | 1.4617 | 1.3812 | 1.0335 | 1.1269 | 1.4083 | 1.3002 | 1.1707 | 0.968 | 1.1513 |
Hit Data
| Dataset | Hit |
|---|---|
| Protein Concentration | – |
| Protein Localization | ✘ |
| Gene Expression | ✔ |
| Translational Efficiency | ✘ |
Endocytosis
| Temp | Actin Patch (Sac6-tdTomato) | Cortical Patch (Sla1-GFP) | Late Endosome (Snf7-GFP) | Vacuole (Vph1-GFP) |
|---|---|---|---|---|
| 37℃ | ||||
| RT |
Cell Cycle Omics
CYCLoPs (Ngl2-GFP)
| Gene / Allele | Actin Patch (Sac6-tdTomato) | Cortical Patch (Sla1-GFP) | Late Endosome (Snf7-GFP) | Vacuole (Sac6-tdTomato) |
|---|
| Gene | Images |
|---|
| Gene | Images |
|---|
Images are not yet available
Images are not yet available